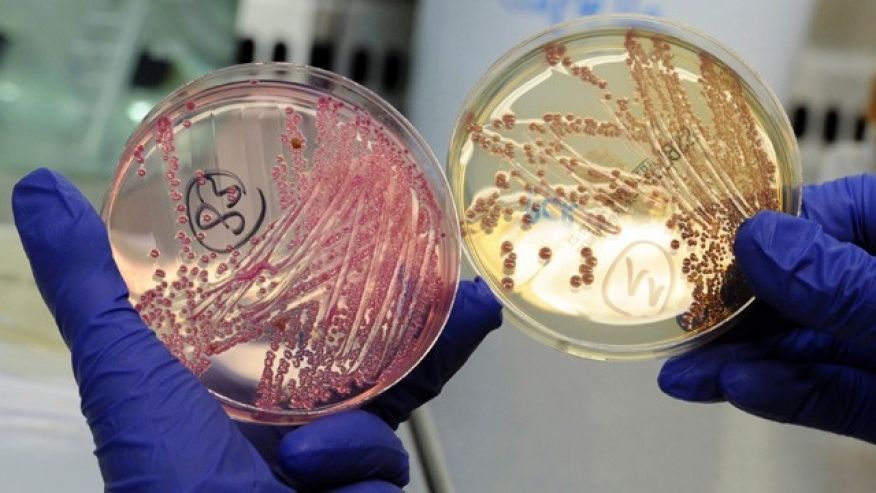

Drug-resistant infections have the potential to cause a level of economic damage similar to—and likely worse than—that caused by the 2008 financial crisis, according to a new report by the World Bank Group. Research shows that a high-case scenario of antimicrobial resistance (AMR)—where antibiotics no longer treat infections the way they are supposed to—could cause low-income countries to lose more than 5% of their GDP and push up to 28 million people, mostly in developing countries, into poverty by 2050. And unlike the financial crisis of 2008, there would be no prospects for a cyclical recovery in the medium term, as the costly impact of AMR would persist, the World Bank website reported. “The scale and nature of this economic threat could wipe out hard-fought development gains and take us away from our goals of ending extreme poverty and boosting shared prosperity,” said Jim Yong Kim, President of the World Bank Group.